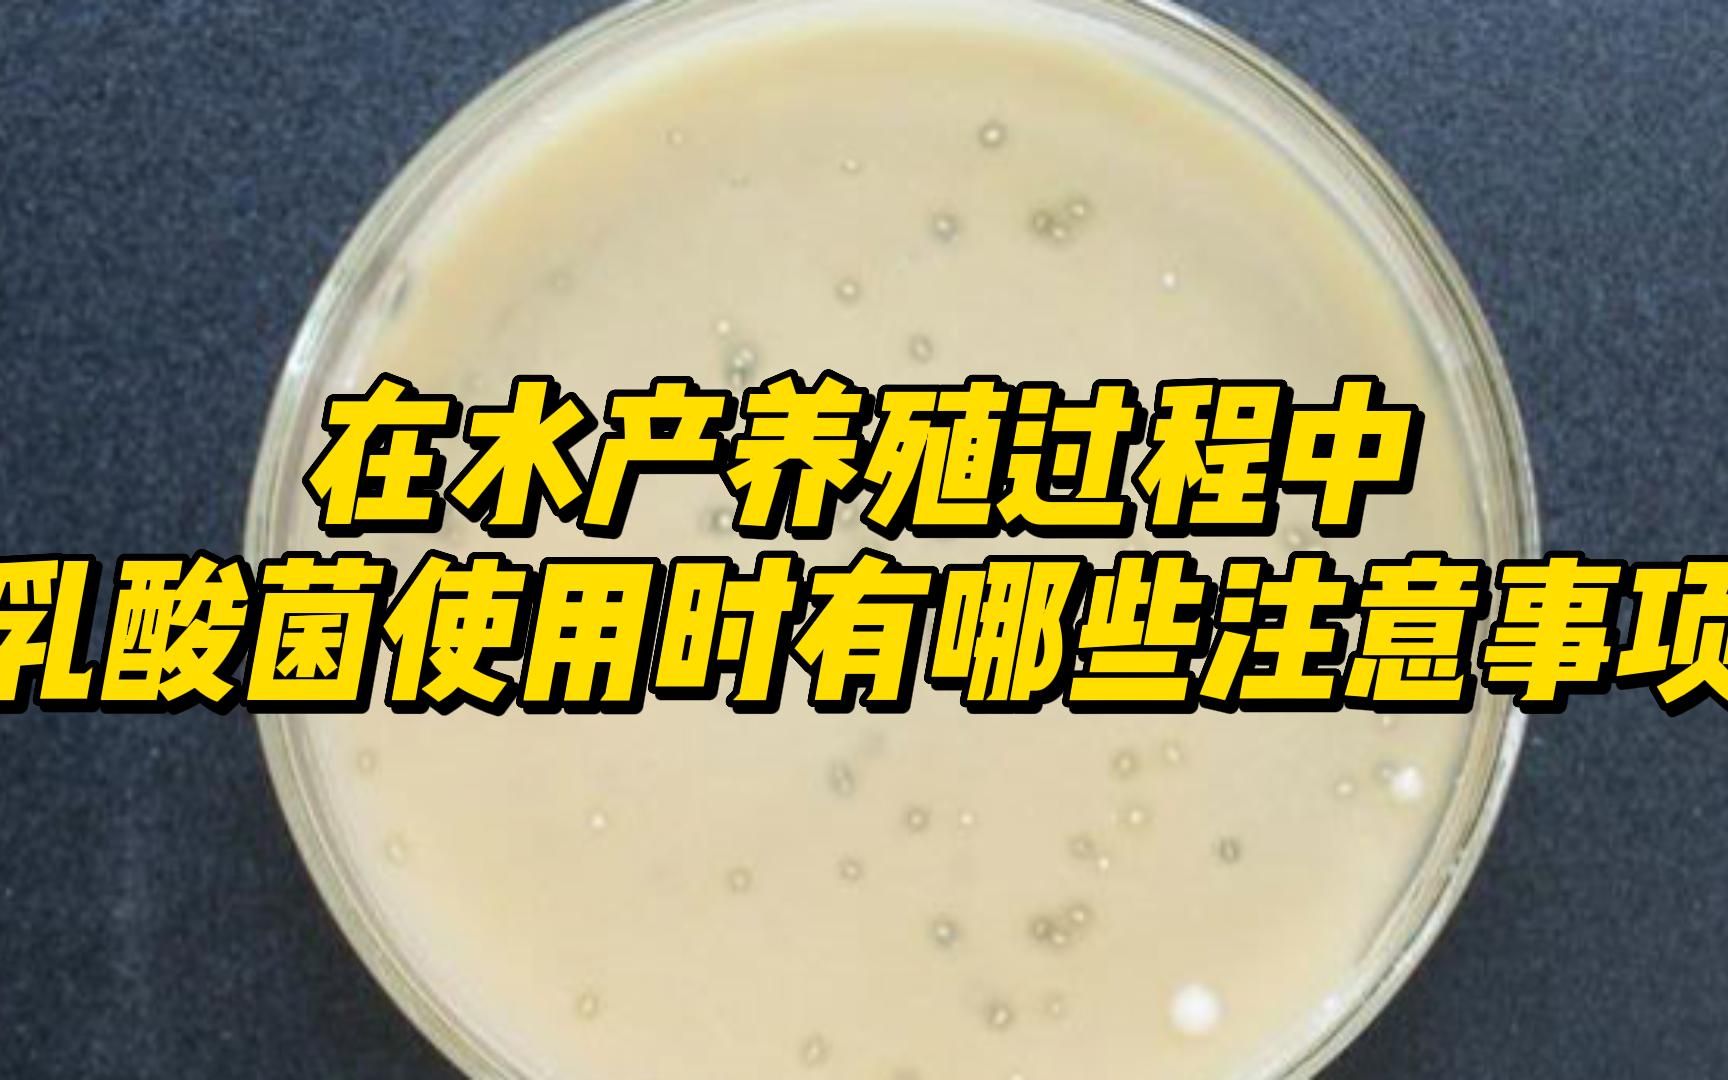
乳酸菌阴胶囊的功效(乳酸菌阴胶囊，维护女性私处健康)

乳酸菌阴胶囊的功效(乳酸菌阴胶囊,维护女性私处健康)
乳酸菌阴胶囊的功效
乳酸菌阴胶囊是一种以乳酸菌为主要成分的保健品,主要用于女性私处的保健。乳酸菌阴胶囊的功效主要体现在以下几个方面:
1. 调节阴道菌群平衡
阴道菌群平衡是女性私处健康的重要保障。乳酸菌阴胶囊中的乳酸菌可以有效地调节阴道菌群平衡,增加有益菌的数量,抑制有害菌的生长,从而预防和治疗阴道炎、霉菌感染等疾病。
·
·
2. 缓解阴道干燥、瘙痒等不适症状
阴道干燥、瘙痒等不适症状是女性私处健康常见的问题。乳酸菌阴胶囊中的乳酸菌可以促进阴道内环境的酸碱度调节,增加阴道内的水分含量,缓解阴道干燥、瘙痒等不适症状。
 ·
·
3. 增强免疫力
乳酸菌阴胶囊中的乳酸菌可以增强人体的免疫力,提高人体抵抗疾病的能力。此外,乳酸菌阴胶囊中还含有多种维生素和矿物质,对人体健康也有很好的保健作用。
4. 预防妇科疾病
乳酸菌阴胶囊可以预防和治疗多种妇科疾病,如阴道炎、霉菌感染、宫颈糜烂等。长期服用乳酸菌阴胶囊可以有效地预防妇科疾病的发生。
5. 改善性生活质量
乳酸菌阴胶囊可以改善女性性生活质量,提高性生活的舒适度和满意度。乳酸菌阴胶囊可以促进阴道内环境的酸碱度调节,增加阴道内的水分含量,从而改善性生活的体验。
6. 促进肠道健康
乳酸菌阴胶囊中的乳酸菌可以促进肠道健康,维护肠道菌群平衡,预防和治疗肠道疾病。长期服用乳酸菌阴胶囊可以促进肠道健康,提高人体免疫力。
7. 无副作用
乳酸菌阴胶囊是一种天然保健品,不含化学成分,无副作用。长期服用乳酸菌阴胶囊可以有效地保护女性私处健康,提高身体免疫力,改善生活质量。
总结
乳酸菌阴胶囊是一种非常适合女性的保健品,具有调节阴道菌群平衡、缓解阴道干燥、瘙痒等不适症状、增强免疫力、预防妇科疾病、改善性生活质量、促进肠道健康等多种功效。长期服用乳酸菌阴胶囊可以有效地保护女性私处健康,提高身体免疫力,改善生活质量。
如果您觉得本文对您有帮助,请关注我们,好东西网将持续分享更多生活知识。
1.《乳酸菌阴胶囊的功效(乳酸菌阴胶囊,维护女性私处健康)》援引自互联网,旨在传递、分享更多网络信息知识,仅代表原作者观点,与本网站无关,侵删请联系站长。
2.《乳酸菌阴胶囊的功效(乳酸菌阴胶囊,维护女性私处健康)》仅供读者参考,本网站未对该内容进行证实,对其原创性、真实性、功效性、完整性、及时性不作任何保证。
3.文章转载时请保留本站内容来源地址:https://haodonxi.com/gongxiao/8264.html
-
蓝莓怎么吃,蓝莓的功效
一、吃法1、生吃:它属于营养价值很高的水果,在购买之后是可以直接生吃的。不过在吃之前要洗净,一般需提前泡上五分钟,来回搅拌几次再冲洗一遍。或者是使用盐水浸泡,之后冲洗后就可以吃了。2、加冰糖:有的人吃不了酸,所以...
-
芳疗有什么功效呢?
今天小编给大家分享:芳疗有什么功效呢?希望能够帮助到大家。 芳疗的核心物质是植物精油,采用蒸馏,压榨或脂提等方法从植物花瓣,树皮,根茎或果实中得来,素有植物激素之称,富有极佳的美疗、保健,调理,治疗的功放。芳疗...
-
冷压蓝莓籽精油,有什么用途和功效
冷压未精致蓝莓籽油被称为抗老化的超级品。冷压获得的蓝莓籽油含有丰富的抗氧化物质,未精致更完整的保留了蓝莓本来的颜色和香气,活性物质更加优越的保存。2、油体质地清爽,能够快速被肌肤吸收,营造肌肤的亚光感,提供活性...
-
蓝莓籽油,护肤美容的佳品
蓝莓不仅吃起来很美味,还是护肤美容的佳品~富含维C,肌肤美白柔滑;且花青素、维A含量丰富。花青素通过对弹性蛋白酶和胶原蛋白酶的抑制,使皮肤变得光滑而富有弹性,从内部和外部同时防止由于过度日晒所导致的皮肤损伤等等。...
-
吃蓝莓有什么好处,蓝莓的皮可以吃吗
一、有什么好处1、增进视力:它里面含有花青素,这种成分经过医学方面的临床报告显示能增进视网膜中的视紫质再生,可预防近视,增进视力。2、抗氧化:花青素是比较有效的一种抗氧化剂,而蓝莓中的花青素成分高,由此就意味着能...
-
蔓越莓籽,蓝莓籽,草莓籽三莓护理油
三莓组合(10ml,蔓越莓5ml:蓝莓2 5ml:草莓2 5ml),再加4d香家玫瑰精油,酸酸甜甜,轻薄好吸收,肤感无敌。草莓籽油:清洁净化力超强,可抗菌和收敛止血(尤其在处理皮肤伤口);可高效降低面部色素沉淀(对老年斑,晒斑...
-
蓝莓籽植物油 香甜的蓝莓味
蓝莓籽油真的就像新鲜的水果蓝莓的蓝莓味的,香甜,涂抹在身上好像一颗行走的大蓝莓。好好闻而且蓝莓籽油的肤感真是绝佳,上脸和身上之后瞬间吸收,皮肤滋润却感受不到有的那种感觉,呈现哑光的状态。香味和颜色真是戳中我的少...
-
玉兰花精油的功效及制作教程(玉兰花精油:美肌神器)
玉兰花精油还可以帮助淡化色斑,使肌肤更加均匀和明亮。玉兰花精油中含有丰富的抗氧化物质,可以防止色素沉淀,减少色斑的形成。玉兰花精油具有缓解疼痛的功效,可以缓解头痛、肌肉疼痛、关节疼痛等不适症状。玉兰花精油中含有...
-
丁香是什么她有那些作用及功效。丁香的功效与作用
丁香是常见的中药材之一,其具有很好的药用价值,一直被人们所喜爱。丁香的功效常常被人们所称道。那么,丁香有什么作用呢?丁香的功效有哪些呢?丁香的保健作用丁香富含丰富的挥发油和丁香酚等成分,这些物质对于肠胃、呼吸、...
-
黑咖啡有什么功效(黑咖啡的7大健康功效,让你更健康)
黑咖啡的功效黑咖啡是一种不加糖、不加奶的咖啡,它含有丰富的咖啡因和抗氧化物质,有很多的功效。提高注意力和警觉性黑咖啡中的咖啡因可以刺激中枢神经系统,提高人的注意力和警觉性。一杯咖啡可以让人保持清醒
-
白花菜子
名称:白花菜子白花菜子【别名】臭菜、臭花菜、羊角菜【来源】白花菜科白花菜属植物白花菜Cleome gynandra L [Gynandropis gynandra
-
白花丹
名称:白花丹白花丹【拼 音】BAIHUADAN【英文名】Whiteflower Leadword Root【拉丁名】药材Radix Plumbaginis Zeylanicae原植物Plumba
-
白花鬼针草
名称:白花鬼针草白花鬼针草:菊科,鬼针草属Agulha Branca WhiteSpanish-needles学名:Bidens alba一年生草本,原产於热带美洲。由於瘦
-
白花蛇
名称:白花蛇白花蛇为蝮蛇科动物尖吻蝮(五步蛇)的干燥全体。主产于湖北、浙江、 江西、福建等地。以条大、干燥、头尾齐全、花纹斑块明显者
-
白花蛇舌草
名称:白花蛇舌草白花蛇舌草(学名:Hedyotis diffusa)是茜草科耳草属的植物。分布在日本以及中国大陆的南方等地,生长于海拔1,800米的地
















